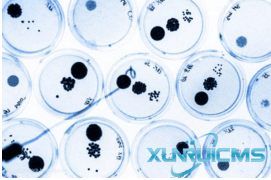
微信圖片_20241029135845 微信圖片_20241029135845

什么是重組胰蛋白酶?
重組胰蛋白酶是指利用基因重組技術(shù)生產(chǎn)的胰蛋白酶Trypsin(Parenzyme),它是絲氨酸蛋白水解酶家族成員之一,屬肽鏈內(nèi)切酶,國(guó)際酶學(xué)編號(hào)為:EC3.4.4.4。
胰蛋白酶的來源及水解特異性
最初發(fā)現(xiàn)并使用的胰蛋白酶是從牛、羊、豬的胰臟提取的,其廣泛存在于在脊椎動(dòng)物和微生物中,不同來源其最適溫度有所不同,其中哺乳動(dòng)物源胰蛋白酶與人體最為相近。
胰臟是胰蛋白酶的前體胰蛋白酶原合成場(chǎng)所,合成后作為胰液的成分而分泌,經(jīng)腸激酶或胰蛋白酶切去前導(dǎo)肽而形成具有活性的胰蛋白酶,為肽鏈內(nèi)切酶,它能把多肽鏈中賴氨酸和精氨酸殘基中的羧基側(cè)切斷,如果酸性殘基位于裂解位點(diǎn)的任一側(cè),則水解速率較慢,如果脯氨酸殘基位于裂解位點(diǎn)的羧基側(cè),則不會(huì)發(fā)生裂解。
胰蛋白酶不僅作為消化酶,同時(shí)還能激活糜蛋白酶原、羧肽酶原、磷脂酶原等其它酶的前體,起激活作用,是特異性最強(qiáng)的蛋白酶。在決定蛋白質(zhì)的氨基酸排列中,它是必不可少的工具酶。

重組胰蛋白酶相對(duì)于動(dòng)物提取胰蛋白酶的優(yōu)點(diǎn)
首先,提高了疫苗的安全性,因?yàn)閯?dòng)物提取胰蛋白酶可能含有致病因子、動(dòng)物病毒、朊蛋白等外源性風(fēng)險(xiǎn)物質(zhì),從而導(dǎo)致在疫苗中的殘留,而重組胰蛋白酶不含這些外來風(fēng)險(xiǎn)物質(zhì)(珠海冀百康的重組胰蛋白酶在生產(chǎn)過程中不使用任何動(dòng)物來源的材料,符合最新發(fā)布的重組胰蛋白酶標(biāo)準(zhǔn))。其次,是產(chǎn)量大幅度提高,降低生產(chǎn)成本、降低分離純化技術(shù)門檻,使之能夠進(jìn)行大規(guī)模生產(chǎn)和商品化應(yīng)用(或工業(yè)化應(yīng)用),且激活后的胰蛋白酶的酶切特異性與動(dòng)物胰腺來源一致。最后,動(dòng)物提取胰蛋白酶由于動(dòng)物來源不同導(dǎo)致批次間差異較大,而重組胰蛋白酶的原材料穩(wěn)定,故產(chǎn)品質(zhì)量穩(wěn)定,批間差異小。
胰蛋白酶在疫苗中生產(chǎn)中的應(yīng)用
疫苗是目前預(yù)防疾病發(fā)生和傳播最為有效的方式,主流生產(chǎn)疫苗的主要方法有:雞胚培養(yǎng)系統(tǒng)和動(dòng)物細(xì)胞培養(yǎng)系統(tǒng)。
目前使用最為廣泛的是動(dòng)物細(xì)胞培養(yǎng)系統(tǒng),動(dòng)物細(xì)胞在適宜環(huán)境下能夠迅速增殖,并且由于其與人體組織細(xì)胞極為相似,故而其生產(chǎn)的疫苗具有很高的免疫原性。傳統(tǒng)的雞胚培養(yǎng)疫苗系統(tǒng)則存在許多不足之處,比如培養(yǎng)的病毒容易發(fā)生變異;與人群流行病毒株存在差異導(dǎo)致疫苗效果不佳或無預(yù)防效果;病毒大范圍傳播時(shí)健康雞胚供應(yīng)受限致使短時(shí)間內(nèi)無法滿足對(duì)疫苗的需求。
1.用于疫苗生產(chǎn)中細(xì)胞培養(yǎng)時(shí)的細(xì)胞解離
貼壁依賴型動(dòng)物細(xì)胞在培養(yǎng)時(shí)都是貼附于固相表面進(jìn)行生長(zhǎng),一般貼附于培養(yǎng)器皿表面或微載體,我們稱之為貼壁培養(yǎng)。細(xì)胞貼壁后迅速鋪展并以有絲分裂的方式進(jìn)行增殖,并很快進(jìn)入對(duì)數(shù)生長(zhǎng)期。數(shù)天后就鋪滿培養(yǎng)表面,并在形成致密的單層細(xì)胞后停止增殖,隨后進(jìn)行放大傳代培養(yǎng),此時(shí)就需要使用細(xì)胞消化液對(duì)貼壁細(xì)胞進(jìn)行處理,使之成為單個(gè)細(xì)胞并且不對(duì)其造成損傷,其中酶類細(xì)胞消化液主要成分為蛋白水解酶和緩沖保護(hù)溶液。當(dāng)前市場(chǎng)上所售以胰蛋白酶消化液為主,胰蛋白酶能夠水解細(xì)胞間的沾粘蛋白,釋放出單個(gè)獨(dú)立細(xì)胞,并且很好的保持細(xì)胞的完整性和細(xì)胞活性。
2.用于疫苗生產(chǎn)中裂解病毒
以細(xì)胞培養(yǎng)系統(tǒng)培養(yǎng)的流感病毒血凝素HA為例:流感病毒血凝素HA被宿主蛋白酶裂解為成熟的HA1和HA2后才能夠介導(dǎo)病毒囊膜與靶細(xì)胞融合,開始病毒生命周期,因此HA的裂解成為病毒感染細(xì)胞的首要因素,因此可以采用外加胰蛋白酶的方式進(jìn)行裂解,以進(jìn)行病毒疫苗的生產(chǎn),其可有效的提高病毒產(chǎn)量,從而進(jìn)行大規(guī)模的生產(chǎn)并簡(jiǎn)化相關(guān)生產(chǎn)工藝。
3.用于消除疫苗生產(chǎn)過程中可能造成的生物危害
當(dāng)前基因工程疫苗是國(guó)際社會(huì)生物安全管理的一個(gè)集中點(diǎn),在基因工程疫苗的研制過程中,經(jīng)過基因重組而攜帶外源基因的生物體一旦逃逸到環(huán)境中,經(jīng)過基因整合后,可能會(huì)引起生態(tài)系統(tǒng)的結(jié)構(gòu)發(fā)生改變,打破其在長(zhǎng)期進(jìn)化過程中所形成的生態(tài)平衡,威脅自然界中的生物,有些病毒具有導(dǎo)致靶組織損傷的基因,可能使原本無害的微生物變得極其危險(xiǎn)。
我國(guó)對(duì)于生物安全相當(dāng)重視,并建立了一整套法律法規(guī)以保障生物安全。胰蛋白酶可用于生產(chǎn)過程中生物危害的消除,病毒粒子主要依靠表面結(jié)構(gòu)進(jìn)行吸附和侵入宿主細(xì)胞,胰蛋白酶能水解并破壞病毒粒子的衣殼蛋白,并造成病毒粒子脂質(zhì)的丟失,從而讓病毒粒子不再具有吸附和侵入能力,進(jìn)而達(dá)到消除可能形成的危害,達(dá)到防患與未然的目的。
參考文獻(xiàn):
[1]孔冬妮.H5亞型禽流感病毒HA基因突變對(duì)其細(xì)胞融合胰酶依賴性的影響及尼帕腦炎重組新城疫病毒活載體疫苗的研究[D].中國(guó)農(nóng)業(yè)科學(xué)院,2012.
[2]江征.穩(wěn)定表達(dá)牛胰蛋白酶的MDCK細(xì)胞的構(gòu)建及對(duì)流感病毒增殖影響的研究[D].中國(guó)食品藥品檢定研究院,2014.
[3]金明蘭,李杭,王盛,楊曉凱.重組流感病毒生物學(xué)特性及環(huán)境安全性[J].吉林建筑工程學(xué)院學(xué)報(bào),2013,30(03):51-54+58.
[4]陳瓊,石繼春,王春娥,王珊珊,葉強(qiáng).不同解吸附處理對(duì)肺炎球菌結(jié)合疫苗各型多糖含量檢測(cè)結(jié)果的影響[J].中國(guó)生物制品學(xué)雜志,2013,26(08):1170-1174.
[5]邵云龍.雞傳染性法氏囊病細(xì)胞活疫苗的研制[D].山東農(nóng)業(yè)大學(xué),2004.
[6]任平,韓雙,徐美佳.模擬生產(chǎn)工藝制作新城疫細(xì)胞凍干苗[J].黑龍江畜牧獸醫(yī),2012(20):103-104.
[7]李明生,李倬,喬自林,馮若飛,馬忠仁,馮玉萍,侯蘭新,張福梅.胰蛋白酶的制備及其在細(xì)胞培養(yǎng)中的應(yīng)用研究[J].天然產(chǎn)物研究與開發(fā),2009,21(06):1011-1014.
